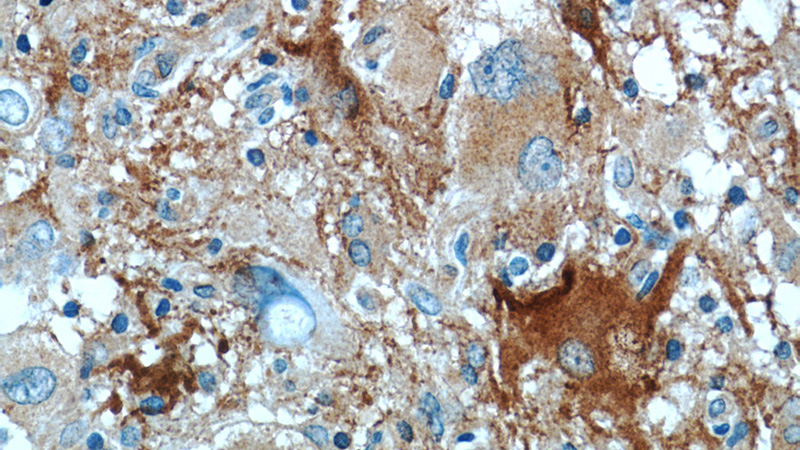
Immunohistochemistry of paraffin-embedded human gliomas tissue slide using Catalog No:108409(BAG3 Antibody) at dilution of 1:50 (under 40x lens)

-
Product Name
BAG3 antibody
- Documents
-
Description
BAG3 Rabbit Polyclonal antibody. Positive IP detected in K-562 cells. Positive WB detected in HeLa cells, DU 145 cells, HEK-293 cells, K-562 cells, mouse brain tissue, mouse placenta tissue, mouse uterus tissue, rat brain tissue. Positive IHC detected in human gliomas tissue. Positive IF detected in Hela cells. Observed molecular weight by Western-blot: 74-80 kDa
-
Tested applications
ELISA, WB, IF, IP, IHC
-
Species reactivity
Human,Mouse,Rat; other species not tested.
-
Alternative names
BAG 3 antibody; BAG3 antibody; BIS antibody; CAIR 1 antibody; DOCking protein CAIR 1 antibody
-
Isotype
Rabbit IgG
-
Preparation
This antibody was obtained by immunization of BAG3 recombinant protein (Accession Number: NM_004281). Purification method: Antigen affinity purified.
-
Clonality
Polyclonal
-
Formulation
PBS with 0.1% sodium azide and 50% glycerol pH 7.3.
-
Storage instructions
Store at -20℃. DO NOT ALIQUOT
-
Applications
Recommended Dilution:
WB: 1:500-1:5000
IP: 1:500-1:5000
IHC: 1:20-1:200
IF: 1:10-1:100
-
Validations

HeLa cells were subjected to SDS PAGE followed by western blot with Catalog No:108409(BAG3 antibody) at dilution of 1:1000

IP Result of anti-BAG3 (IP:Catalog No:108409, 4ug; Detection:Catalog No:108409 1:1000) with K-562 cells lysate 11000ug.

Immunofluorescent analysis of Hela cells, using BAG3 antibody Catalog No:108409 at 1:25 dilution and Rhodamine-labeled goat anti-rabbit IgG (red).

Immunohistochemistry of paraffin-embedded human gliomas tissue slide using Catalog No:108409(BAG3 Antibody) at dilution of 1:50 (under 10x lens)
Immunohistochemistry of paraffin-embedded human gliomas tissue slide using Catalog No:108409(BAG3 Antibody) at dilution of 1:50 (under 40x lens)
-
Background
BAG3 (Bcl2-associated athanogene 3) belongs to the BAG protein family, the co-chaperone that binds to Hsc70/Hsp70 through the BAG domain and modulates their activity in polypeptide folding. BAG3 contains also a WW domain and a proline-rich (PXXP) repeat, that mediate binding to partners different from Hsp70. Through interacting with different molecular partner, BAG3 influences several cell processes, such as apoptosis, autophagy and cell motility. BAG3 protein has been reported to sustain cell survival, resistance to therapy, and/or motility and metastatization in several tumor types, thus being identified as a potential target for anticancer therapies. In addition, defects in BAG3 are the cause of some myopathy. BAG3 normally migrates around 74-80 kD; a slightly different molecular weight or a doublet form can be observed in some cell types and/or following cell exposure to stressors. A synaptosome associated form of 40 kD has recently been described.
-
References
- Xu Z, Graham K, Foote M. 14-3-3 protein targets misfolded chaperone-associated proteins to aggresomes. Journal of cell science. 126(Pt 18):4173-86. 2013.
- Merabova N, Sariyer IK, Saribas AS. WW domain of BAG3 is required for the induction of autophagy in glioma cells. Journal of cellular physiology. 230(4):831-41. 2015.
- Ulbricht A, Eppler FJ, Tapia VE. Cellular mechanotransduction relies on tension-induced and chaperone-assisted autophagy. Current biology : CB. 23(5):430-5. 2013.
- Muñoz-Moreno R, Barrado-Gil L, Galindo I, Alonso C. Analysis of HDAC6 and BAG3-aggresome pathways in African swine fever viral factory formation. Viruses. 7(4):1823-31. 2015.
- Lei Z, Brizzee C, Johnson GV. BAG3 facilitates the clearance of endogenous tau in primary neurons. Neurobiology of aging. 36(1):241-8. 2015.
- Ulbricht A, Gehlert S, Leciejewski B, Schiffer T, Bloch W, Höhfeld J. Induction and adaptation of chaperone-assisted selective autophagy CASA in response to resistance exercise in human skeletal muscle. Autophagy. 11(3):538-46. 2015.
- Vanoli A, Necchi V, Barozzi S, Manca R, Pecci A, Solcia E. Chaperone molecules concentrate together with the ubiquitin-proteasome system inside particulate cytoplasmic structures: possible role in metabolism of misfolded proteins. Histochemistry and cell biology. 144(2):179-84. 2015.
- Arndt V, Dick N, Tawo R. Chaperone-assisted selective autophagy is essential for muscle maintenance. Current biology : CB. 20(2):143-8. 2010.
Related Products / Services
Please note: All products are "FOR RESEARCH USE ONLY AND ARE NOT INTENDED FOR DIAGNOSTIC OR THERAPEUTIC USE"
